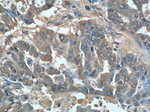
AFP Antibody in Immunohistochemistry (Paraffin) (IHC (P))
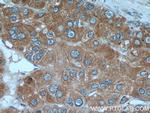
AFP Antibody in Immunohistochemistry (Paraffin) (IHC (P))

Search
Proteintech
AFP Polyclonal Antibody
{{$productOrderCtrl.translations['antibody.pdp.commerceCard.promotion.promotions']}}
{{$productOrderCtrl.translations['antibody.pdp.commerceCard.promotion.viewpromo']}}
{{$productOrderCtrl.translations['antibody.pdp.commerceCard.promotion.promocode']}}: {{promo.promoCode}} {{promo.promoTitle}} {{promo.promoDescription}}. {{$productOrderCtrl.translations['antibody.pdp.commerceCard.promotion.learnmore']}}
产品信息
14550-1-AP
种属反应
已发表种属
宿主/亚型
分类
类型
抗原
偶联物
形式
浓度
规格
纯化类型
保存液
内含物
保存条件
运输条件
产品详细信息
Immunogen sequence: LDVAHVHEH CCRGDVLDCL QDGEKIMSYI CSQQDTLSNK ITECCKLTTL ERGQCIIHAE NDEKPEGLSP NLNRFLGDRD FNQFSSGEKN IFLASFVHEY SRRHPQLAVS VILRVAKGYQ ELLEKCFQTE NPLECQDKGE EELQKYIQES QALAKRSCGL FQKLGEYYLQ NAFLVAYTKK APQLTSSELM AITRKMAATA ATCCQLSEDK LLACGEGAAD IIIGHLCIRH EMTPVNPGVG QCCTSSYANR RPCFSSLVVD ETYVPPAFSD DKFIFHKDLC QAQGVALQTM KQEFLINLVK QKPQITEEQL EAVIADFSGL LEKCCQGQEQ EVCFAEEGQK LISKTRAALG V (260-609 aa encoded by BC027881)
靶标信息
AFP (Alpha Fetoprotein) is a major plasma protein produced by the yolk sac, intestinal tract and the liver during fetal life. AFP expression in adults is often associated with hepatoma or teratoma. However, hereditary persistence of AFP may also be found in individuals with no obvious pathology. The protein is thought to be the fetal counterpart of serum albumin, and AFP and albumin genes are present in tandem in the same transcriptional orientation on chromosome 4. AFP is found in monomeric, dimeric, and trimeric forms. AFP can also bind to copper ions, nickel ions, fatty acids and bilirubin. The level of AFP in amniotic fluid is used to measure renal loss of protein to screen for spina bifida and anencephaly. High level of serum AFP has been identified in patients with hepatocellular carcinomas (HCC), teratoblastoma, colorectal cancer, pancreatic cancer, and germ cell neoplasms.
仅用于科研。不用于诊断过程。未经明确授权不得转售。
生物信息学
蛋白别名: a fetoglobulin; a fetoprotein; Alpha fetoglobulin; Alpha-1-fetoprotein; Alpha-fetoglobulin; Alpha-fetoprotein; alpha-foetoprotein; chloride intracellular channel 6; fetoglobulin; fetoprotein; unnamed protein product; α fetoglobulin; α fetoprotein
基因别名: AFP; AFPD; FETA; HPAFP
UniProt ID: (Human) P02771, (Mouse) P02772
Entrez Gene ID: (Human) 174, (Rat) 24177, (Mouse) 11576